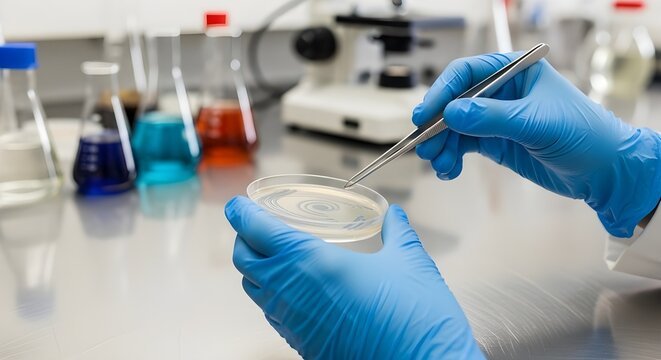
Laboratory technician handling test tubes filled with liquid samples - Powered by Adobe

- Home >
- Stock Photos >
- Lab Technician Handling Frozen Test Tubes in Scientific Laboratory
Lab Technician Handling Frozen Test Tubes in Scientific Laboratory Image

Laboratory technician carefully handling frozen test tubes, demonstrating the crucial role of precision and accuracy in medical testing and scientific research. Useful for content emphasizing scientific research, healthcare themes, or illustrating the importance of methodical processes in medical environments.
3
downloads
downloads
Tags:
More
Credit Photo
If you would like to credit the Photo, here are some ways you can do so
Text Link
photo Link
<span class="text-link">
<span>
<a target="_blank" href=https://pikwizard.com/photo/lab-technician-handling-frozen-test-tubes-in-scientific-laboratory/432722517ef14dfcead32196d02c2058/>PikWizard</a>
</span>
</span>
<span class="image-link">
<span
style="margin: 0 0 20px 0; display: inline-block; vertical-align: middle; width: 100%;"
>
<a
target="_blank"
href="https://pikwizard.com/photo/lab-technician-handling-frozen-test-tubes-in-scientific-laboratory/432722517ef14dfcead32196d02c2058/"
style="text-decoration: none; font-size: 10px; margin: 0;"
>
<img src="https://pikwizard.com/pw/medium/432722517ef14dfcead32196d02c2058.jpg" style="margin: 0; width: 100%;" alt="" />
<p style="font-size: 12px; margin: 0;">PikWizard</p>
</a>
</span>
</span>
Free (free of charge)
Free for personal and commercial use.
Author: People Creations